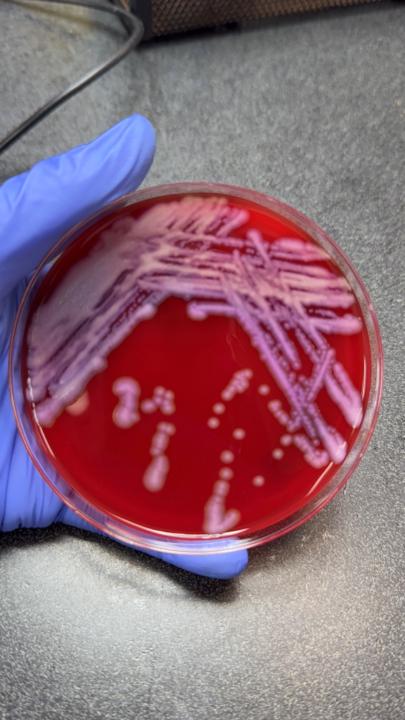
Hailey Roenner

Activity
Mon
Wed
Fri
Sun
Apr
May
Jun
Jul
Aug
Sep
Oct
Nov
Dec
Jan
Feb
Mar
What is this?
Less
More
Memberships
Microscope Views
136 members • $87/month
Microscope Views (FREE)
1.8k members • Free
1 contribution to Microscope Views (FREE)
🧫 ASCP Practice Question Breakdown
Let’s go through this question step-by-step because this is a great example of how biochemicals and clinical context will lead you straight to the right answer (if you’ve studied your foundational organisms and their “bread-and-butter biochemicals“). Case Info: A pure culture of gram-negative rods was isolated from pulmonary secretions of a 10-year-old cystic fibrosis patient with pneumonia. ***Right away, before we even look at the biochemical data, “cystic fibrosis” + “pulmonary secretions” should make a few key organisms pop into your head 🧫 Biochemical Profile: - Oxidase = + - OF Glucose (open) = + - Red pigment (non-fluorescent) - Growth at 42°C = + - Motility = + - Gelatin hydrolysis = + - Arginine dihydrolase = + - Flagella = polar, monotrichous Which is the most likely organism? A. Burkholderia pseudomallei B. Pseudomonas stutzeri C. Burkholderia cepacia D. Pseudomonas aeruginosa Marilyn’s Thought Process: Let’s say you don’t immediately recognize the bug. That’s okay. This is how I’d narrow it to 2 before deciding: 1. Think about what Cystic Fibrosis is. If you don’t know, then look at other clues. It says pulmonary secretions and pneumonia. You gotta at LEAST know what pneumonia is… 2. Next, you have to eliminate at least two of these. Two choices are Burkholderia and two are Pseudomonas. Clearly, they’re trying to get you to narrow it down, but it might be tricky because (assuming you know what cystic fibrosis is)… CF patients are highly susceptible to Pseudomonas AND Burkholderia spp. 3. Oxidase (+) and Growth at 42°C are strong differentiators. Only certain Pseudomonas spp. reliably grow at 42°C. 4. Red, non-fluorescent pigment rules out P. fluorescens and similar fluorescent species. 5. Arginine dihydrolase +, gelatin hydrolysis +, and polar monotrichous flagella further point toward a specific profile. 📌 Bottom Line: Even if you’re stuck between Burkholderia cepacia and Pseudomonas aeruginosa, the oxidase positivity and growth at 42°C should lock in your answer. That combination is biochemically distinctive, so you just need to know your core organisms cold.
1-1 of 1